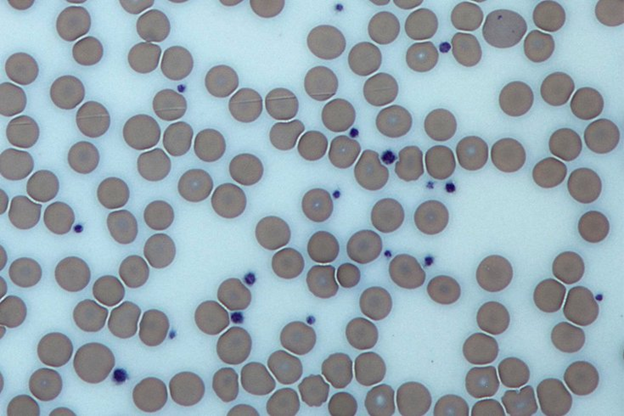

A Mediterranean Diet For Breast Cancer Prevention
A Mediterranean style diet is an ideal diet to reduce the risk of breast cancer. Specifically, it is low in saturated fat and red meat, and high in fiber. Fats The type of fat a woman eats is important. A meta-analysis showed that death from breast cancer was higher in the women eating more […]
A Mediterranean Diet For Breast Cancer Prevention Read More »